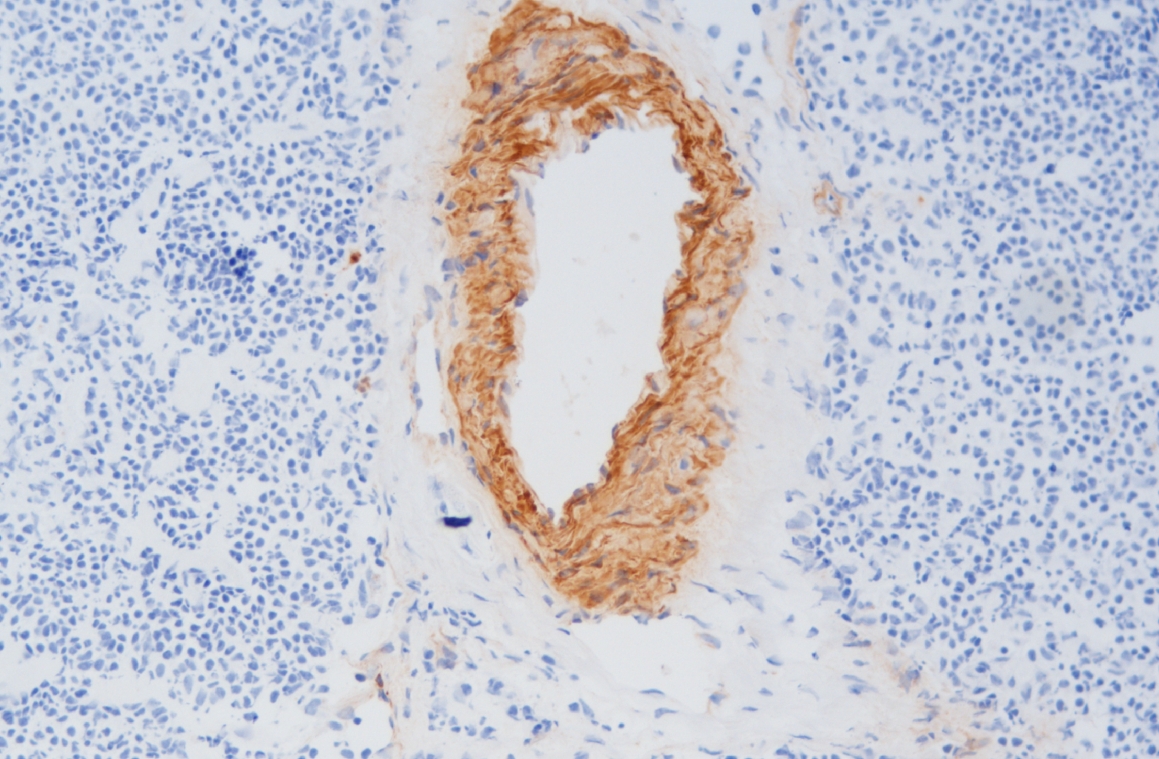

赛诺特生物
郑州市肿瘤病理精准诊断院士工作站
郑州市病理诊断工程技术研究中心
河南省肿瘤病理诊断试剂工程技术研究中心
你的当前位置:
免疫组化抗体试剂
自研一抗超100种,提供优质病理级免疫组化抗体
多色免疫组化
十分钟诊断,百分百信心
在术中获取更多的肿瘤标记物信息提升诊断准确率
鸡尾酒抗体染色与顺次染色灵活选择,适用于多种不同抗体组合,满足病理科的临床与科研需求
术中快速冰冻免疫组化
免疫显色系统
国内首创新一代MicroStackerr微聚合物二抗检测系统,突破四大核心技术,并可实现鼠兔同步放大,获得国家发明专利,打破进口垄断
辅助用品
提供配套辅助用品